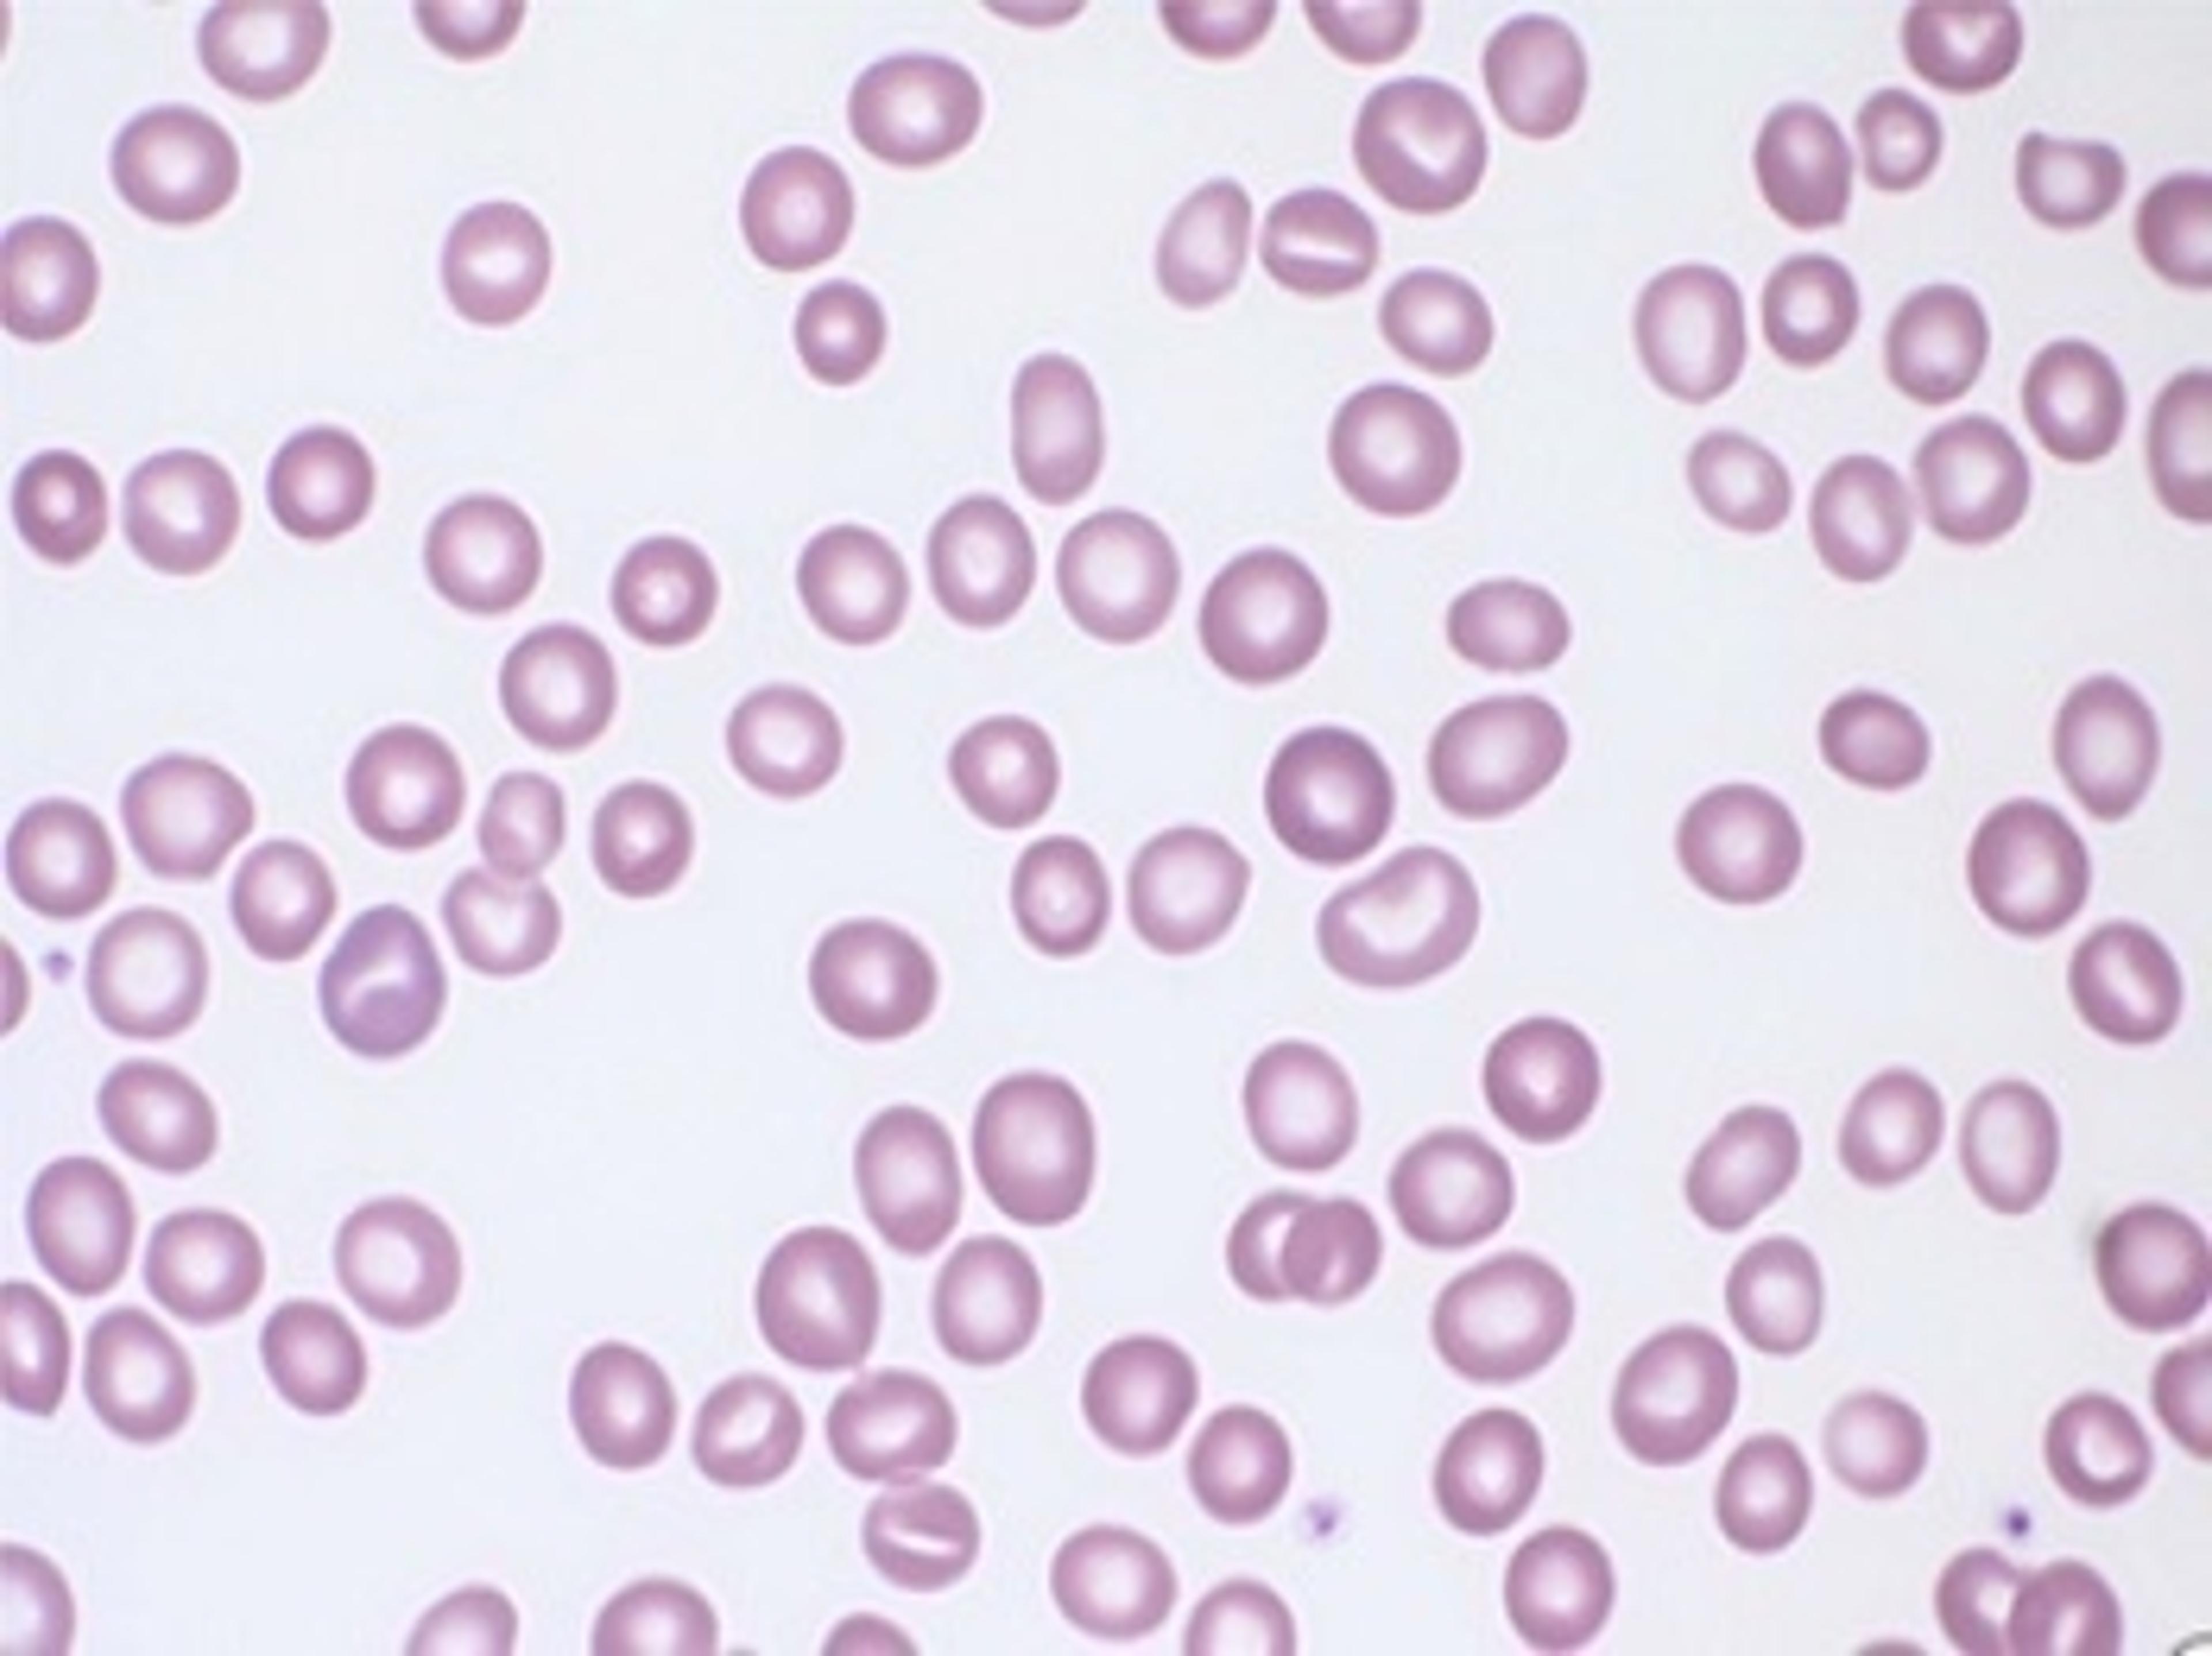

HT-2H
Holotomography combined with 3D fluorescence imaging
The supplier does not provide quotations for this product through SelectScience. You can search for similar products in our Product Directory.
Great technlogy , it is my main work equipment
Holotomography
It is all I need these days for my researcher. Easy, fast, convenient. Great and fast support. Price was affordable compared to the great output.
Review Date: 28 Mar 2023 | Tomocube
Exceptional resolution, quality and ease of use. Automated stage + AI enabled software.
Biomedicine
Ultra-high resolution microscope for 3D analysis of cell morphology, stiffness, structure and motility. Unique capabilities and correlative fluorescent/confocal imaging.
Review Date: 16 Apr 2019 | Tomocube
The HT-2H, a holotomography imaging system that displays both 3D holograms and 3D fluorescence imaging, is able to deliver researchers to new frontiers of understanding cellular dynamics and diagnosing diseases. The HT-2H opens a new era of 3D correlative imaging, combining holotomography and fluorescence methods. HT-2H allows conventional epifluorescence imaging for labeling any specific target (organelles or proteins) in 3D holotomography, minimizing the photodamage of the live cells.
- Correlative microscopy in one instrument : HT-2H provides high-quality 3D images of both holotomography and 3D fluorescence z-stack images for each sample. There are three excitation wavelengths (385 nm, 470 nm, 570 nm) and a motorized Z-stage (step resolution: 150 nm).
- Quantitative data marked with fluorescence : HT-2H provides morphological (volume, surface area, projection area, and sphericity), chemical (dry mass, concentration), and mechanical (cell deformability) properties of cells with 3D refractive index (RI) tomogram. Moreover, fluorescence images provide information about molecular specificity.
- Minimal stress on cells : Simultaneous measurement capability of time-lapse 3D RI tomography and fluorescence image allows long-time tracking of specific targets in live cells. The fluorescence image provides the position of specific target organelles or structures in live cells, and consecutive measurement of time-lapse 3D RI tomography enables monitoring the cellular structures with minimal stress.